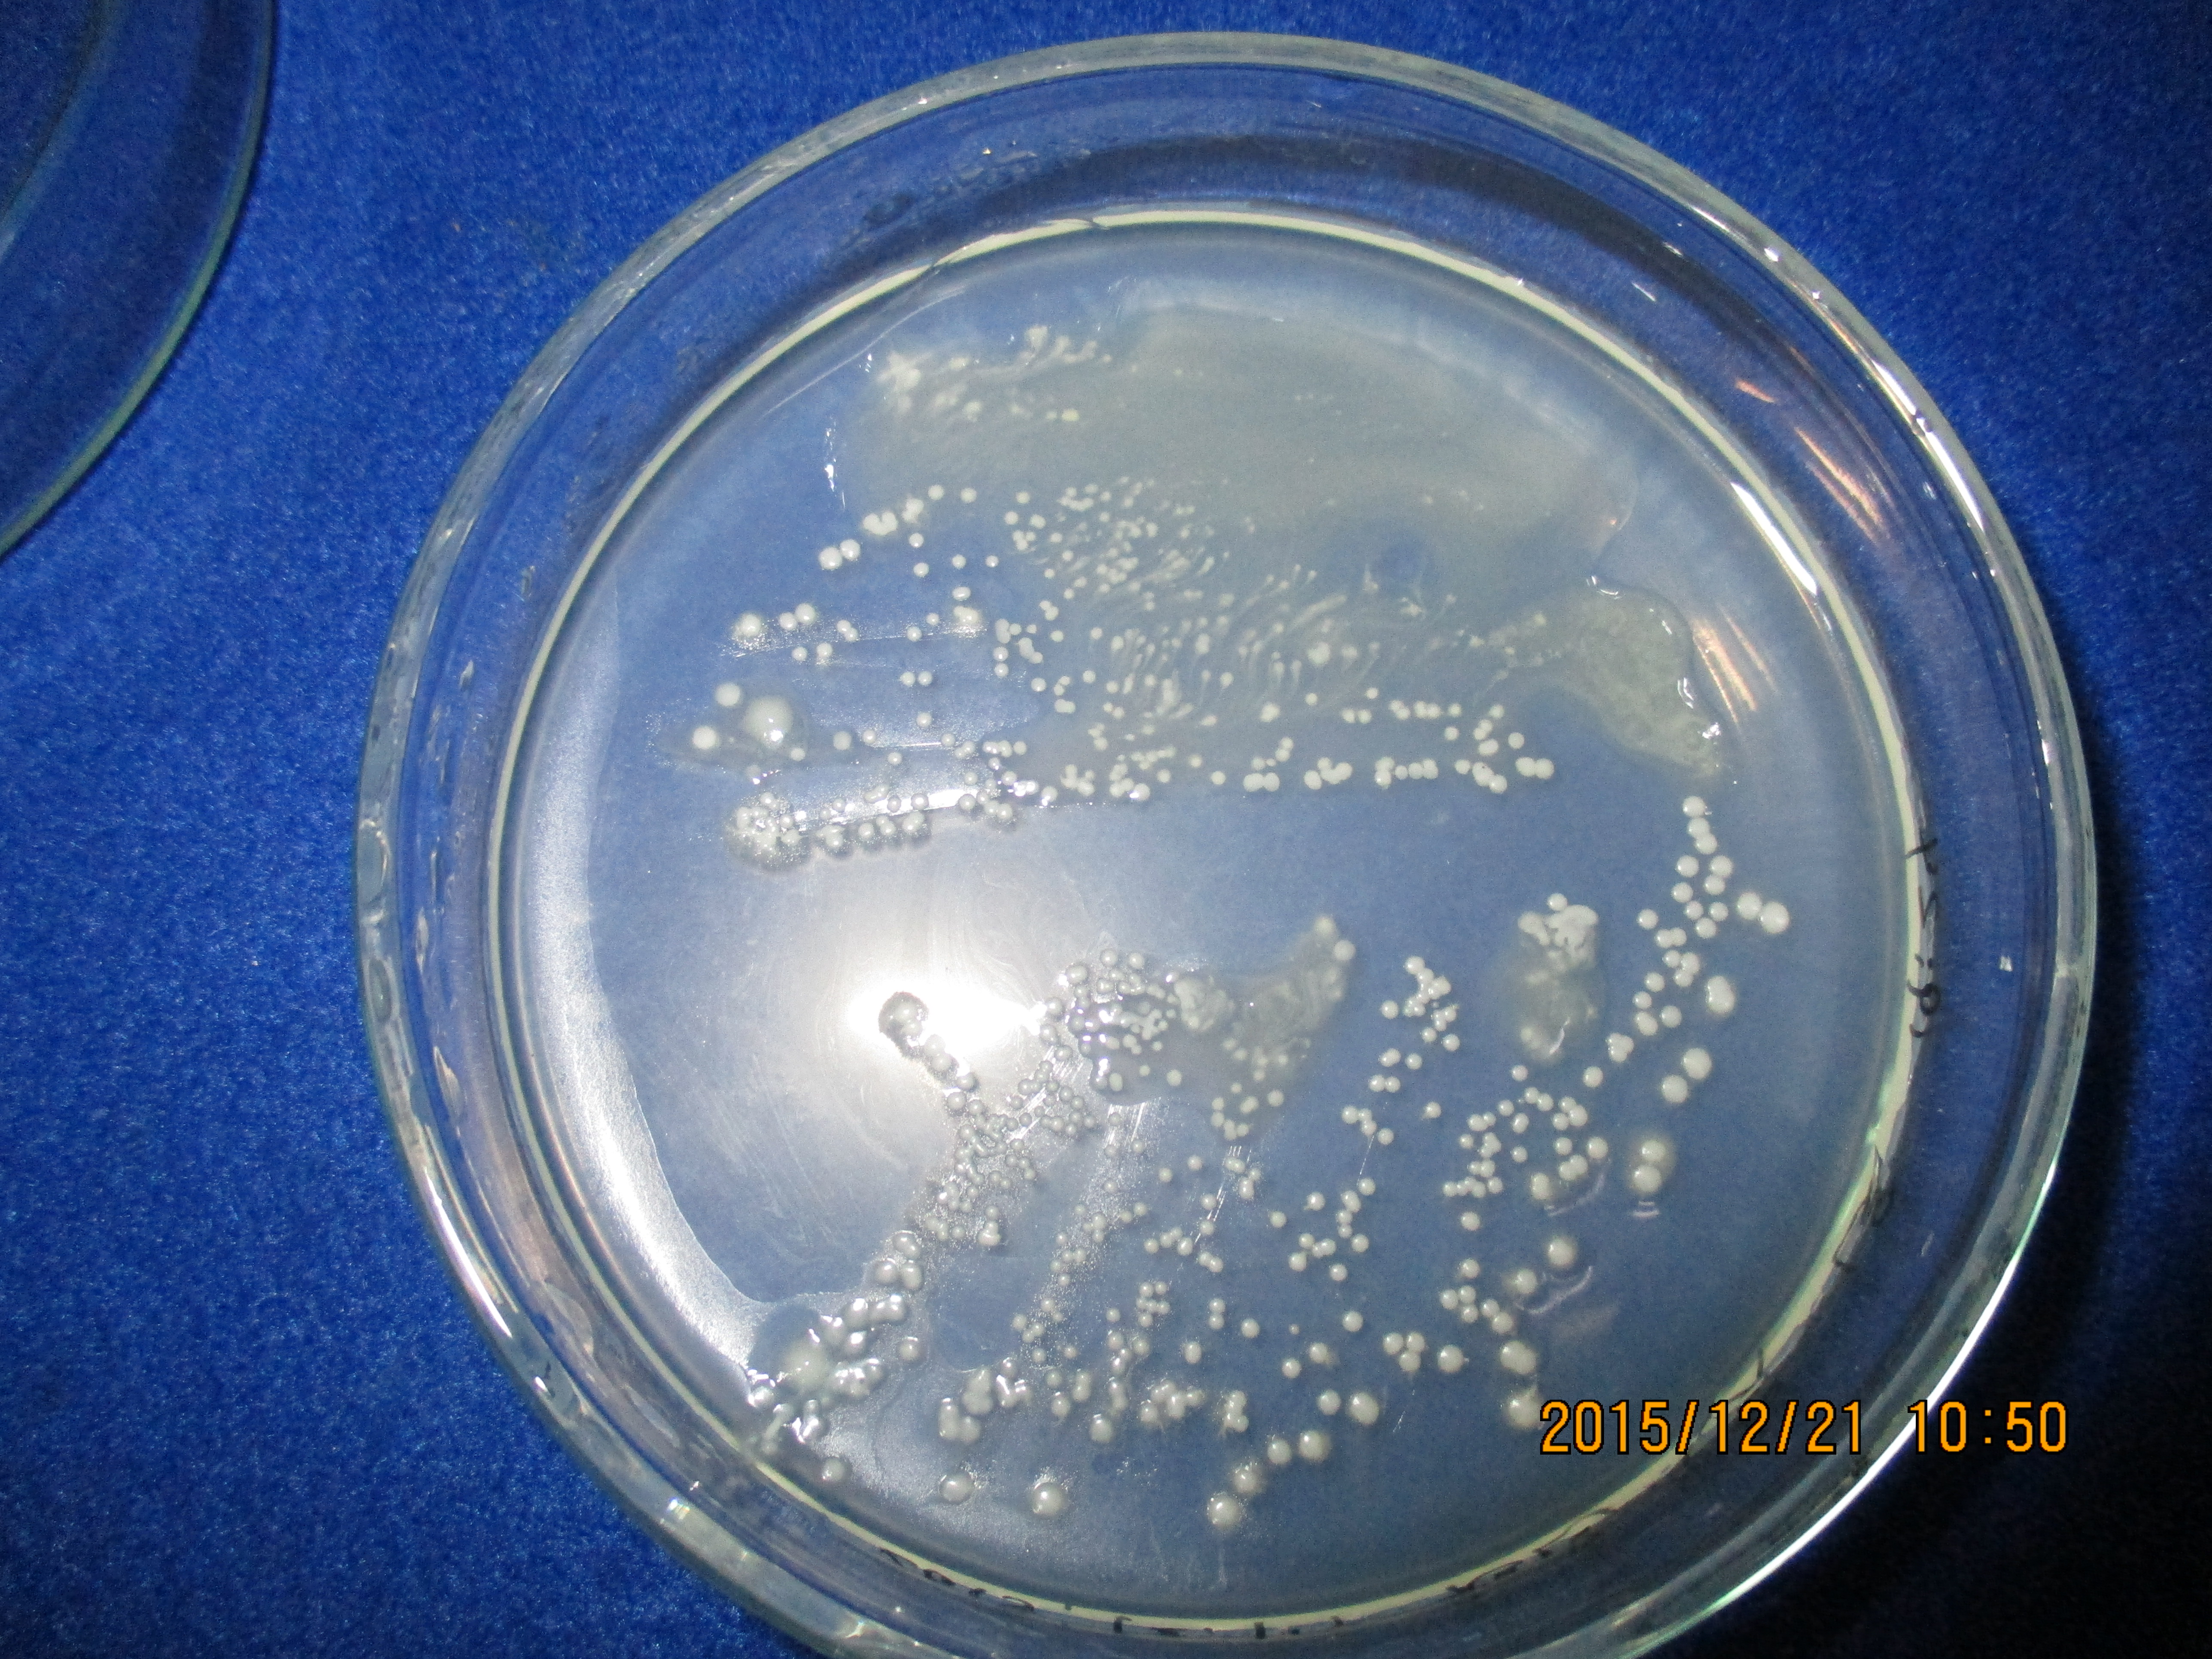

4-3.細菌培養検査
1)臨床における難治性治療の増加
HPで述べていますよう、現在は「MRSA」に代表される「薬剤(抗菌剤)耐性菌」の増加によって既存の抗菌剤では治療困難になっているため欧米医療従事者の切迫した重大問題となっています。同様にむし歯や歯周病においても薬剤耐性菌による難治症例の増加がみられます。2.細菌に対して医師・歯科医師は敗北しつつある。
2)解決には詳細な細菌情報が必要
このような症例に対して正確な診断、適切な治療を実行するためには「薬剤耐性菌」だけに囚われず、常に病巣部全般の詳細な細菌情報(細菌の種類と生態)を掌握する必要があります。また、これらの細菌情報をデータベース化しておく必要があります。
3)細菌培養の目的
診療の限られた時間内で位相差顕微鏡検査だけでは病巣部の細菌の性状や生態を十分に観察する事は困難です。そのためFDCでは病巣部から検体を採取、好気性、嫌気性の2条件で細菌培養を行ないます。この培養された細菌から詳細な細菌情報を得ると共に臨床技術の向上に役立たせます。培養の目的は以下の通りです。
3-1.培養目的
-
病巣部に存在する細菌の「性状と生態」の究明
-
歯科用薬剤耐性細菌の「特性と生態」に関する観察
-
臨床における診断精度の向上
-
適切な抗菌剤投与の判断
-
病原菌除菌技術の開発
4)細菌培養のメリット
例えば、患者さんへの抗菌剤の投薬が適切になり広範囲の抗菌剤を投薬しないことで薬剤耐性菌をつくらないなどのメリットがあります。さらに、目的に述べていますようにコロニーの細菌を用いて新しい治療法をシュミレーションすることもできます。
以下にFDCの日常的に実施しています細菌培養の一部を紹介致します。
5)検体の採取部位
検体は病巣部を中心に採取しますが、それ以外にも必要な部位から採取します。なお、検体は偏性嫌気性菌の存在を前提に採取後、10分以内に培地を各培養条件(好気性、嫌気性)に分けてインキュベーターに収納します。また、この間のコンタミネーション(汚染)防止には十分な注意を払っています。
5-1.検体の採取部位
-
むし歯の場合
- 病巣部でレーザー検査値の最も高い部位
-
根管治療の場合
- 根管内、但し、必要に応じて根管の内壁、フィステル(歯肉の排膿部)など
-
歯周病の場合
- 病状により採取部位を歯周ポケット表層部から歯周ポケットの底部までの最適部位、フィステル(歯肉の排膿部)など
-
智歯(親知らず)周囲炎の場合
- 採取部位は歯周病に準じます。
-
感染症が疑われる場合
- 病巣部を中心に必要に応じて複数箇所から採取
6)検体の培養方法
培養は培地へのコンタミネーション(汚染)を防止するために無菌的環境の元で操作いたします。使用培地も滅菌処理されたものを使用致します。
-
◆1.培養環境
好気性菌は空気中で培養可能ですが、偏性嫌気性菌は空中で30分間被曝させますと死滅します。そのため偏性嫌気性菌の培養は容器内が無酸素で二酸化炭素濃度5%の嫌気ジャーで培養します。FDCは偏性嫌気性菌を含む検体は10分以内にインキュベータ(培養器)内の嫌気ジャーに収容します。また、培養温度は34℃に設定し培地のPH変化に注意します。培養期間は菌種に応じて24時間から1週間程度まで必要です。
-
◆2.栄養条件(培地)
細菌は培養環境だけでなく「栄養条件(培地)」によっても細菌培養の成否が生じます。そこで、培養に先立ちMS培地、バイオメデカルNHM-Ⅱ(ヒツジ血液培地)やさらには嫌気性菌の場合はPVDブルセラHK寒天培地(ウサギノ血液培地)など様々な培地を準備しておかなければなりません。病巣部の細菌培養の成否は適切な培地の選択が重要な要素です。
7)コロニー(集落)の検査
まず、コロニーの色や形状を観察し、細菌の特徴をつかみます。例えば選択培地である血液寒天培地ではPrevotella spp. Porphyromonas spp.などの黒色色素による特徴的コロニーを形成します。
次に、これらのコロニーをつかってグラム染色法や顕微鏡検査など色々な標準検査を行ないます。また、FDCでは診断や治療用に開発しました独自の検査法も追加しています。
-
◆1.グラム染色検査
細菌細胞膜構造の違い利用してグラム染色しますとグラム陽性菌とグラム陰性菌を区別することができます。このグラム染色法によって細菌の細胞膜が一層か、二層かを区別ができますので抗菌剤投与の際の大変重要な細菌情報です。また、FDC病原菌除菌法の手段を選択するだけでなく制圧時間を推測する場合にも有益な検査です。 Phot-7.グラム染色された細菌
Phot-5.グラム陽性菌
Phot-6.グラム陰性菌
-
◆2.病原菌除菌検査
コロニーの細菌は抗菌剤の効果判定試験に利用するだけでなく、FDC式の制圧法(溶菌・除去)をシュミレーションすることができます。例えばFDC式制圧法に使用する「物理的条件」や「化学的な条件」を変化させることによって得られた制圧効果や制圧効率を基に信頼性の高い制圧技術に改善していきます。
「偏性嫌気性菌」の制圧はFDCではルーティン化されていますので「好気性菌」に対する制圧技術を以下に示します。
-
Scientific treatment principle of FDC
-
Regular checkup -
The necessity of bacterial examination
-
About bacteria
-
Bacterial culture test
-
The world of phase contrast microscopy. -
Laser treatment&Treatment cases
-
Treatment for loose teeth by periodontal disease
-
Criteria for extracting teeth
-
Advanced integrated medical information system.
-
High standard prosthesis.(Electromyogram /Pronunciation analysis ) -
Safety management
-
Infection control technology.
-
Technical education of personnel.
-
Quality Control System.
-
Holistic Medicine.
-
Preventive training program.
-
Dental information for patients.
-
Patient's evaluation.
-
FDC's mental and physical health method.
-
For FDC patients only.
- Profile of the director
-
About Disclaimer.